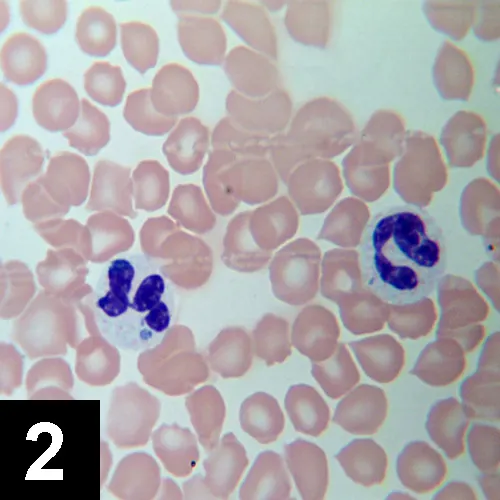
Featured Image

History
The owner had observed lethargy and inappetence for the past 2 days. The dog became lame the morning before presentation. It was presented in the summer and resides in western Washington state (Olympic peninsula). It had no history of travel during the 6 months before presentation or of concurrent disease.
Physical Examination
Physical examination abnormalities were fever (103.9° F) and mild dehydration (2%). Lameness was evident during the physical examination, and orthopedic examination elicited pain on palpation of the right stifle joint. Joint effusion, neurologic deficits, and cardiac abnormalities were not detected. Abdominal palpation revealed no abnormalities. No lymphadenopathy was found.
Laboratory Analysis
Complete blood count and a serum chemistry profile were done (Table). Hematologic abnormalities included leukopenia with lymphopenia and mild-to-moderate neutropenia.

Thrombocytopenia was observed. Mild, normocytic, normochromic, nonregenerative anemia was identified. Blood smear examination revealed small basophilic inclusions in some neutrophils (Figure 1). Serum biochemical abnormalities were mild and nonspecific. Increased alkaline phosphatase values were noted. Urinalysis was unremarkable. Fecal examination was normal. Arthrocentesis was not performed.
Diagnosis: Infection with Anaplasma phagocytophilum
Interpretation
Blood smear examination revealed morulae-like structures in 32% of neutrophils. Infected neutrophils generally contained one inclusion, although two or more were occasionally found (Figure 2). Inclusions were identified in neutroplils but not in other leukocytes.
Intragranulocytic morulae are consistent with Anaplasma phagocytophilum (formerly Ehrlichia equi) or Ehrlichia ewingii infection. Anaplasma phagocytophilum is a newly designated tick-borne pathogen joining together three previously described species: Ehrlichia equi, Ehrlichia phagocytophilum, and Human Granulocytic Agent. The disease caused by A. phagocytophilum was formerly known as granulocytic ehrlichiosis but it is now called granulocytic anaplasmosis.
Anaplasma phagocytophilum causes granulocytic inclusions in domestic dogs, horses, cattle, sheep, goats, llamas, cats, and humans. This infection has been described in Washington state, California, the upper midwestern and northeastern regions of the United States, British Columbia, and Europe. It is a tick-borne disease transmitted by Ixodes pacificus in the western United States and Ixodes scapularis in the midwestern and eastern United States. Incidence depends on the seasonality of the tick vector.
Responsible for fever, lethargy, and anorexia, the infection causes lameness in some dogs (acute polyarthritis). Anemia is not always observed, but thrombocytopenia is common. In dogs, granulocytic inclusions caused by A. phagocytophilum must be differentiated from granulocytic inclusions caused by E. ewingii. Ehrlichia ewingii infection occurs in the southern United States and causes an acute polyarthritic disorder characterized by fever, anorexia, lameness, mild thrombocytopenia without bleeding diatheses, and mild nonregenerative anemia.
Additional Testing
Serologic and PCR testing were performed. Serologic testing for A. phagocytophilum was positive at a titer of 1/640 but negative for E. canis. Because E. ewingii infection is identified by the presence of antibodies reactive to E. canis antigen, it was confirmed that the infection was caused by A. phagocytophilum.
Treatment
The dog was treated with doxycycline (5 to 10 mg/kg PO Q 12 to 24 H) for 21 days. A favorable and rapid response was reported within 2 days. Resolution of the clinical signs was observed 24 to 48 hours after initiation of doxycycline. The patient remains clinically healthy 3 months later.
Infection with A. phagocytophilum should be considered a diagnostic differential for dogs presenting with lethargy, anorexia, and fever, particularly in the context of lameness, lymphopenia, thrombocytopenia, and increased alkaline phosphatase levels. Identification of canine granulocytic anaplasmosis in a region should increase surveillance for A. phagocytophilum in humans and horses in the region.
ASK YOURSELF ...
• What are the differential diagnoses for fever/anorexia/limping?• What are the differential diagnoses of the intracytoplasmic structures present in the neutrophils? Which additional tests could help differentiate among them?• What additional tests should be done if no organisms are observed?
DID YOU ANSWER ...
• Trauma, joint infection, ehrlichiosis, anaplasmosis, Rocky Mountain spotted fever, Lyme disease.• Artifacts, toxic changes, Ehrlichia ewingii morulae, or Anaplasma phagocytophilum morulae. Two morulae can be found in one neutrophil and are easily differen-tiated by microscopic evaluation. Serologic evaluation is used to differentiate E. ewingii from A. phagocytophilum. Seroconversion occurs 2 to 5 days after the first appearance of morulae in peripheral blood. Currently, dogs with E. ewingii infection are identified by the presence of antibodies reactive to E. canis antigen and/or E. ewingii- specific PCR. They do not generally produce antibodies reactive to A. phagocytophilum antigen.• If no organism is observed in peripheral blood, antibodies reactive to E. canis, A. phagocytophilum, Rocky Mountain spotted fever, and Lyme disease should be measured serologically. If only IFA is used, a four-fold increase in titers between the acute and convalescent phases of the infection is necessary for a definitive diagnosis of active infection.
Nomenclature
Anaplasma phagocytophilum is a newly designated tick-borne pathogen that joins together three previously described species: Ehrlichia equi, Ehrlichia phagocytophilum, and Human Granulocytic Agent. This new classification was justified on the basis of a high degree of similarity in the 16S rRNA gene among these three organisms and with any Anaplasma species. Organisms from the order Richettsiales that currently infect small animals are Anaplasma phagocytophilum, Anaplasma platys (formerly Ehrlichia platys), Ehrlichia canis, and Ehrlichia ewingii.